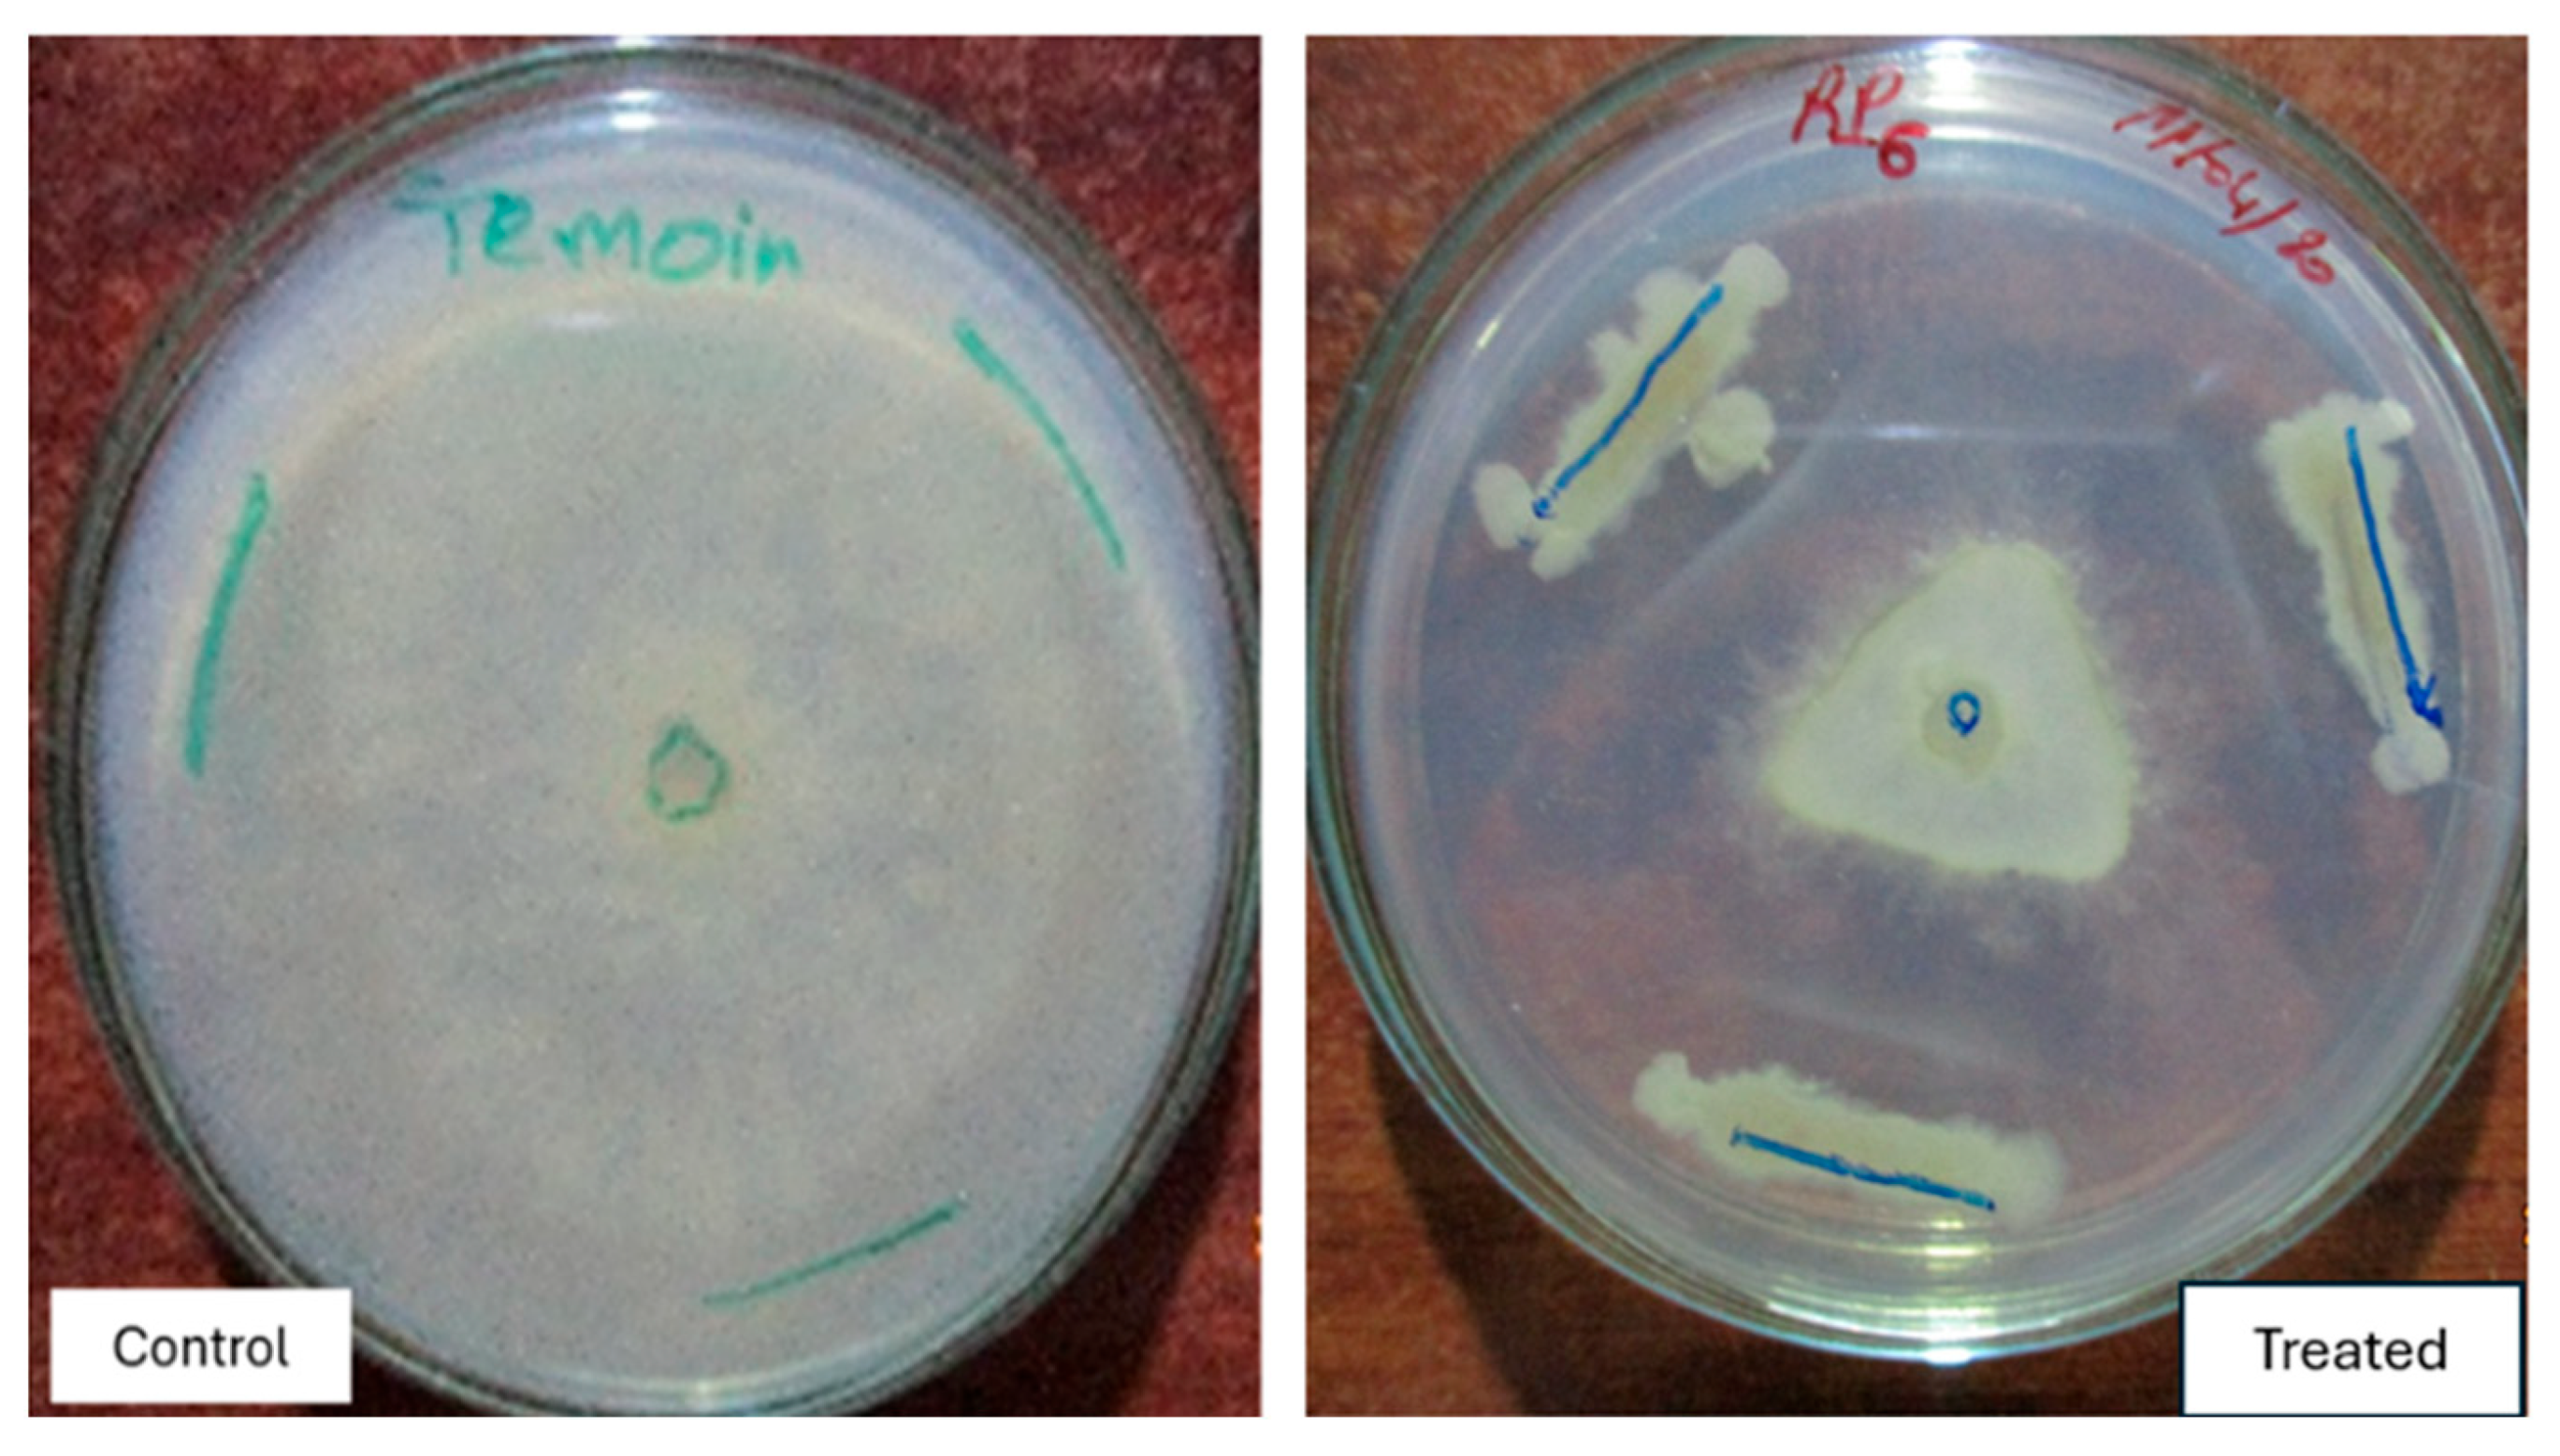
Life 15 00997 g007

Enhancement of Tomato Growth Through Rhizobacteria and Biocontrol of Associated Diseases
Abstract
1. Introduction
2. Materials and Methods
2.1. Isolation and Preparation of Bacterial Strains
2.2. Screening of Plant Growth-Promoting Traits
2.3. Germination and Growth Promotion Assays
2.4. Greenhouse Evaluation
2.5. In Vitro Antagonism Against Fungal Pathogens
2.6. Analysis of Antagonistic Mechanisms
2.7. Molecular Characterization
2.8. Statistical Analysis
3. Results
3.1. Isolation and Purification of Bacterial Isolates
3.2. In Vitro Results of PGPR Isolates
3.3. In Vitro Effect of Isolates on Seed Germination and Shoot Length
3.4. Greenhouse Seed Germination and Seedling Height Measurement
3.5. In Vivo Effect of Isolates on Plant Growth
3.6. Biocontrol Effect of Selected Isolates
3.7. Antagonism Mechanism
3.8. Molecular Identification
4. Discussion and Conclusions
Supplementary Materials
Author Contributions
Funding
Data Availability Statement
Conflicts of Interest
References
- Yadav, D.K.; Devappa, V.; Kashyap, A.S.; Kumar, N.; Rana, V.S.; Sunita, K.; Singh, D. Boosting the Biocontrol Efficacy of Bacillus amyloliquefaciens DSBA-11 through Physical and Chemical Mutagens to Control Bacterial Wilt Disease of Tomato Caused by Ralstonia solanacearum. Microorganisms 2023, 11, 1790. [Google Scholar] [CrossRef] [PubMed]
- Bloemberg, G.V.; Lugtenberg, B.J. Molecular Basis of Plant Growth Promotion and Biocontrol by Rhizobacteria. Curr. Opin. Plant Biol. 2001, 4, 343–350. [Google Scholar] [CrossRef] [PubMed]
- Vessey, J.K. Plant growth promoting rhizobacteria as biofertilizers. Plant Soil 2003, 255, 571–586. [Google Scholar] [CrossRef]
- Qessaoui, R.; Bouharroud, R.; Furze, J.N.; El Aalaoui, M.; Akroud, H.; Amarraque, A.; Van Vaerenbergh, J.; Tahzima, R.; Mayad, E.H.; Chebli, B. Applications of New Rhizobacteria Pseudomonas Isolates in Agroecology via Fundamental Processes Complementing Plant Growth. Sci. Rep. 2019, 9, 12832. [Google Scholar] [CrossRef]
- Qessaoui, R.; Lahmyed, H.; Ajerrar, A.; Furze, J.N.; Timothy, P.; Alouani, M.; Chebli, B.; Mayad, E.; Bouharroud, R. Rhizospheric Solutions: Pseudomonas Isolates Counter Botrytis cinerea on Tomato. Afr. Mediterr. Agric. J.—Al Awamia 2021, 50–72. [Google Scholar] [CrossRef]
- Elhjouji, H.; Qessaoui, R.; Houmairi, H.; Dari, K.; Bencharki, B.; Mayad, E.H.; Aassila, H. Biocontrol Potential of Bacillus velezensis RS65 Against Phytophthora infestans: A Sustainable Strategy for Managing Tomato Late Blight. Microorganisms 2025, 13, 656. [Google Scholar] [CrossRef]
- Goswami, S.K.; Kashyap, A.S.; Kumar, R.; Gujjar, R.S.; Singh, A.; Manzar, N. Harnessing Rhizospheric Microbes for Eco-friendly and Sustainable Crop Production in Saline Environments. Curr. Microbiol. 2023, 81, 14. [Google Scholar] [CrossRef] [PubMed]
- Rahmoune, B.; Morsli, A.; Khelifi-Slaoui, M.; Khelifi, L.; Strueh, A.; Erban, A.; Kopka, J.; Prell, J.; van Dongen, J.T. Isolation and Characterization of Three New PGPR and Their Effects on the Growth of Arabidopsis and Datura Plants. J. Plant Interact 2016, 12, 1–6. [Google Scholar] [CrossRef]
- Chabbi, N.; Chafiki, S.; Telmoudi, M.; Labbassi, S.; Bouharroud, R.; Tahiri, A.; Mentag, R.; El Amri, M.; Bendiab, K.; Hsissou, D.; et al. Plant-Growth-Promoting Rhizobacteria Improve Seeds Germination and Growth of Argania spinosa. Plants 2024, 13, 2025. [Google Scholar] [CrossRef]
- O’COnnell, P.F. Sustainable Agriculture-A Valid Alternative. Outlook Agric 1992, 21, 5–12. [Google Scholar] [CrossRef]
- Esitken, A.; Ercisli, S.; Karlidag, H.; Sahin, F. Potential Use of Plant Growth Promoting Rhizobacteria (PGPR) in Organic Apricot Production. In Proceedings of the international scientific conference: Environmentally friendly fruit growing, Tartu, Estonia, 7–9 September 2005; Tartu University Press: Polli, Estonia, 2005; pp. 90–97. [Google Scholar]
- Burr, T.; Schroth, M.; Suslow, T. Increased Potato Yields by Treatment of Seed Pieces with Specific Strains of Pseudomonas fluorescens and P. putida. Phytopathology 1978, 68, 1377. [Google Scholar] [CrossRef]
- Chabot, R.; Antoun, H.; Cescas, M.P. Stimulation de la croissance du maïs et de la laitue romaine par des microorganismes dissolvant le phosphore inorganique. Can. J. Microbiol. 1993, 39, 941–947. [Google Scholar] [CrossRef]
- Kloepper, J.W. Plant Growth-Promoting Rhizobacteria on Radishes. In Proceedings of the 4th International Conference on Plant Pathogenic Bacter, Station de Pathologie Vegetale et Phytobacteriologie, Angers, France, 1 January 1978; INRA: Angers, France, 1978; pp. 879–882. [Google Scholar]
- Schippers, B.; Bakker, A.W.; Bakker, P.A.H.M. Interactions of Deleterious and Beneficial Rhizosphere and the Effect of Cropping Practices. Annu. Rev. Phytopathol. 1987, 25, 339–358. [Google Scholar] [CrossRef]
- Suslow, T.V. Rhizobacteria of Sugar Beets: Effects of Seed Application and Root Colonization on Yield. Phytopathology 1982, 72, 199. [Google Scholar] [CrossRef]
- Qessaoui, R.; Chafiki, S.; Mahroug, A.; Chabbi, N.; Assri, S.E.; Ajerrar, A.; Hallam, J.; Tahiri, A.; Naima, A.A.; Alouani, M.; et al. Harnessing the Power of Pseudomonas for Sustainable Agriculture: Biofertilization and Biocontrol. Afr. Mediterr. Agric. J.—Al Awamia 2025, 67–89. [Google Scholar] [CrossRef]
- Wu, X.; Liu, Y.; Jia, B.; Tao, L.; Li, H.; Wang, J.; Yuan, Z.; Sun, X.; Yao, Y. Four Decades of Bacillus Biofertilizers: Advances and Future Prospects in Agriculture. Microorganisms 2025, 13, 187. [Google Scholar] [CrossRef] [PubMed]
- Kashyap, A.S.; Manzar, N.; Nebapure, S.M.; Rajawat, M.V.S.; Deo, M.M.; Singh, J.P.; Kesharwani, A.K.; Singh, R.P.; Dubey, S.C.; Singh, D. Unraveling Microbial Volatile Elicitors Using a Transparent Methodology for Induction of Systemic Resistance and Regulation of Antioxidant Genes at Expression Levels in Chili against Bacterial Wilt Disease. Antioxidants 2022, 11, 404. [Google Scholar] [CrossRef]
- Narware, J.; Singh, S.P.; Chakma, J.; Ranjan, P.; Behera, L.; Das, P.; Manzar, N.; Kashyap, A.S. Enhancing Tomato Growth and Early Blight Disease Resistance through Green-Synthesized Silver Nanoparticles: Insights into Plant Physiology. S. Afr. J. Bot 2024, 166, 676–689. [Google Scholar] [CrossRef]
- Sultana, S.; Alam, S.; Karim, M.M. Screening of Siderophore-Producing Salt-Tolerant Rhizobacteria Suitable for Supporting Plant Growth in Saline Soils with Iron Limitation. J. Agric. Food Res. 2021, 4, 100150. [Google Scholar] [CrossRef]
- Abbass, Z.; Okon, Y. Plant Growth Promotion by Azotobacter paspali in the Rhizosphere. Soil Biol. Biochem. 1993, 25, 1075–1083. [Google Scholar] [CrossRef]
- Egamberdiyeva, D. Plant-Growth-Promoting Rhizobacteria Isolated from a Calcisol in a Semi-Arid Region of Uzbekistan: Biochemical Characterization and Effectiveness. J. Plant Nutr. Soil Sci. 2005, 168, 94–99. [Google Scholar] [CrossRef]
- Kashyap, A.S.; Manzar, N.; Rajawat, M.V.S.; Kesharwani, A.K.; Singh, R.P.; Dubey, S.C.; Pattanayak, D.; Dhar, S.; Lal, S.K.; Singh, D. Screening and Biocontrol Potential of Rhizobacteria Native to Gangetic Plains and Hilly Regions to Induce Systemic Resistance and Promote Plant Growth in Chilli against Bacterial Wilt Disease. Plants 2021, 10, 2125. [Google Scholar] [CrossRef]
- Gutiérrez-Mañero, F.J.; Ramos-Solano, B.; Probanza, A.; Mehouachi, J.; Tadeo, F.R.; Talon, M. The Plant-Growth-Promoting Rhizobacteria Bacillus pumilus and Bacillus licheniformis Produce High Amounts of Physiologically Active Gibberellins. Physiol. Plant 2001, 111, 206–211. [Google Scholar] [CrossRef]
- Salamone, I.E.G.d.; Hynes, R.K.; Nelson, L.M. Cytokinin Production by Plant Growth Promoting Rhizobacteria and Selected Mutants. Can. J. Microbiol. 2001, 47, 404–411. [Google Scholar] [CrossRef] [PubMed]
- Kushwaha, C.; Tripathi, S.; Singh, K. Soil Organic Matter and Water-Stable Aggregates under Different Tillage and Residue Conditions in a Tropical Dryland Agroecosystem. Appl. Soil Ecol. 2001, 16, 229–241. [Google Scholar] [CrossRef]
- Jeon, J.; Lee, S.; Kim, H.; Ahn, T. Plant Growth Promotion in Soil by Some Inoculated Microorganisms. J. Microbiol. 2003, 41, 271276. [Google Scholar]
- Mishra, R.; Prakash, O.; Alam, M.; Dikshit, A. Influence of Plant Growth Promoting Rhizobacteria (PGPR) on the Productivity of Pelargonium graveolens L. Herit. Recent Res. Sci. Technol. 2010, 2, 53–57. [Google Scholar]
- Perveen, S.; Ehteshamul-Haque, S.; Ghaffar, A. Efficacy of Pseudomonas aeruginosa and Paecilomyces lilacinus in the Control of Root Rot-Root Knot Disease Complex on Some Vegetables. Nematol. Mediterr. 1998, 26, 209–212. [Google Scholar]
- Raaijmakers, J.M.; Weller, D.M. Exploiting Genotypic Diversity of 2,4-Diacetylphloroglucinol-Producing Pseudomonas spp.: Characterization of Superior Root-Colonizing P. fluorescens Strain Q8r1-96. Appl. Environ. Microbiol. 2001, 67, 2545–2554. [Google Scholar] [CrossRef]
- Weller, D.M.; Raaijmakers, J.M.; Gardener, B.B.M.; Thomashow, L.S. Microbial Populations Responsible for Specific Soil Suppressiveness to Plant Pathogens. Annu. Rev. Phytopathol. 2002, 40, 309–348. [Google Scholar] [CrossRef]
- Amkraz, N.; Boudyach, E.H.; Boubaker, H.; Bouizgarne, B.; Ben Aoumar, A.A. Screening for Fluorescent Pseudomonades, Isolated from the Rhizosphere of Tomato, for Antagonistic Activity toward Clavibacter michiganensis Subsp. Michiganensis. World J. Microbiol. Biotechnol. 2009, 26, 1059–1065. [Google Scholar] [CrossRef]
- Munir, N.; Hanif, M.; Abideen, Z.; Sohail, M.; El-Keblawy, A.; Radicetti, E.; Mancinelli, R.; Haider, G. Mechanisms and Strategies of Plant Microbiome Interactions to Mitigate Abiotic Stresses. Agronomy 2022, 12, 2069. [Google Scholar] [CrossRef]
- Van Loon, L.C.; Glick, B.R. Increased Plant Fitness by Rhizobacteria. In Molecular Ecotoxicology of Plants; Ecological Studies; Sandermann, H., Ed.; Springer: Berlin/Heidelberg, Germany, 2004; Volume 170. [Google Scholar]
- Samaras, A.; Roumeliotis, E.; Ntasiou, P.; Karaoglanidis, G. Bacillus subtilis MBI600 Promotes Growth of Tomato Plants and Induces Systemic Resistance Contributing to the Control of Soilborne Pathogens. Plants 2021, 10, 1113. [Google Scholar] [CrossRef] [PubMed]
- Choudaker, K.R.; Singh, V.K.; Kashyap, A.S.; Patel, A.V.; Sameriya, K.K.; Yadav, D.; Manzar, N.; Kamil, D.; Prasad, L.; Saharan, M.S. Evaluating the Efficacy of Microbial Antagonists in Inducing Resistance, Promoting Growth, and Providing Biological Control against Powdery Mildew in Wheat. Front Microbiol. 2024, 15, 1419547. [Google Scholar] [CrossRef]
- Tirry, N.; Kouchou, A.; El Omari, B.; Ferioun, M.; El Ghachtouli, N. Improved Chromium Tolerance of Medicago Sativa by Plant Growth-Promoting Rhizobacteria (PGPR). J. Genet. Eng. Biotechnol. 2021, 19, 149. [Google Scholar] [CrossRef] [PubMed]
- Baldani, V.L.D.; Döbereiner, J. Host-Plant Specificity in the Infection of Cereals with Azospirillum spp. Soil Biol. Biochem. 1980, 12, 433–439. [Google Scholar] [CrossRef]
- Goswami, D.; Patel, K.; Parmar, S.; Vaghela, H.; Muley, N.; Dhandhukia, P.; Thakker, J.N. Elucidating Multifaceted Urease Producing Marine Pseudomonas aeruginosa BG as a Cogent PGPR and Bio-Control Agent. Plant Growth Regul. 2014, 75, 253–263. [Google Scholar] [CrossRef]
- Ashour, W.E.; Zohair, M.M.; El-Beih, A.A.; Hamed, E.R.; Abd El Aty, A.A. Biochemical Characterization and Ecofriendly Field Application of the Plant Growth-Promoting Rhizobacterium Bacillus amyloliquefaciens MH046937 Isolated From. J. Appl. Pharm. Sci. 2022, 12, 94–105. [Google Scholar] [CrossRef]
- Divyanshu, K.; Yadav, M.; Shukla, V.; Kumar, S.; Tripathi, Y.N.; Upadhyay, R.S. Molecular Identification and Characterization of Plant Growth Promoting Rhizobacteria and their Effect on Seed Germination and Vigour Index of Barley (Hordeum vulgare L.). J. Pure Appl. Microbiol. 2022, 16, 974–989. [Google Scholar] [CrossRef]
- Gordon, S.A.; Weber, R.P. Colorimetric Estimation of Indoleacetic Acid. Plant Physiol. 1951, 26, 192–195. [Google Scholar] [CrossRef]
- Kavino, M.; Harish, S.; Kumar, N.; Saravanakumar, D.; Samiyappan, R. Effect of Chitinolytic PGPR on Growth, Yield and Physiological Attributes of Banana (Musa spp.) under Field Conditions. Appl. Soil Ecol. 2010, 45, 71–77. [Google Scholar] [CrossRef]
- Schwyn, B.; Neilands, J. Universal Chemical Assay for the Detection and Determination of Siderophores. Anal. Biochem. 1987, 160, 47–56. [Google Scholar] [CrossRef]
- Karthika, S.; Midhun, S.J.; Jisha, M. A Potential Antifungal and Growth-Promoting Bacterium Bacillus sp. KTMA4 from Tomato Rhizosphere. Microb. Pathog. 2020, 142, 104049. [Google Scholar] [CrossRef] [PubMed]
- Bouaoud, Y.; Troulet, C.; Foughalia, A.; Berge, O.; Aissat, K.; Bardin, M. A Multi-Criteria Approach for the Selection of Efficient Biocontrol Agents against Botrytis cinerea on Tomato in Algeria. BioControl 2017, 63, 299–311. [Google Scholar] [CrossRef]
- Padder, S.A.; Rather, R.A.; Bhat, S.A.; Shah, M.D.; Baba, T.R.; Mubarak, N.M. Dynamics, Phylogeny and Phyto-Stimulating Potential of Chitinase Synthesizing Bacterial Root Endosymbiosiome of North Western Himalayan Brassica rapa L. Sci. Rep. 2022, 12, 6742. [Google Scholar] [CrossRef]
- Foughalia, A.; Bouaoud, Y.; Chandeysson, C.; Djedidi, M.; Tahirine, M.; Aissat, K.; Nicot, P. A Cinetobacter Calcoaceticus SJ19 and Bacillus Safensis SJ4, Two Algerian Rhizobacteria Protecting Tomato Plants against Botrytis Cinerea and Promoting Their Growth. Egypt. J. Biol. Pest. Control 2022, 32, 12. [Google Scholar] [CrossRef]
- Chauhan, A.; Guleria, S.; Balgir, P.P.; Walia, A.; Mahajan, R.; Mehta, P.; Shirkot, C.K. Tricalcium Phosphate Solubilization and Nitrogen Fixation by Newly Isolated AneuriniBacillus aneurinilyticus CKMV1 from Rhizosphere of Valeriana jatamansi and Its Growth Promotional Effect. Braz. J. Microbiol. 2017, 48, 294–304. [Google Scholar] [CrossRef] [PubMed]
- Ekesi, S.; De Meyer, M.; Mohamed, S.A.; Virgilio, M.; Borgemeister, C. Taxonomy, Ecology, and Management of Native and Exotic Fruit Fly Species in Africa. Annu. Rev. Entomol. 2016, 61, 219–238. [Google Scholar] [CrossRef]
- Mahawer, A.K.; Sharma, R.M.; Dubey, A.K.; Awasthi, O.P.; Singh, D.; Kesharwani, A.K.; Kashyap, A.S.; Sharma, N.; Kulshreshtha, A.; Kumar, A.; et al. Deciphering the Genetic Response: Differential Gene Expression Profiling in Citrus aurantifolia (Chrism.) and Citrus limon (L.) Burm Infected with Xanthomonas citri pv. citri. Trop. Plant Biol. 2025, 18, 22. [Google Scholar] [CrossRef]
- Kaur, R. Characterization of Selected Isolates Of Nonpathogenic Fusarium oxysporum, Fluorescent Pseudomonads and Their Efficacy Against Chickpea Wilt. Ph.D. Thesis, Punjab Agricultural University, Ludhiana, India, 2003. [Google Scholar]
- Liu, Y.; Zhang, W.; Zhang, Z.; Kou, Z.; Wang, X.; Wang, Y.; Su, X.; Zhang, J.; Liu, L.; Yan, F.; et al. Biocontrol Eff. Three Antagon. Bact. Strains Against Codonopsis Pilosula Wilt Dis. Caused By Fusarium oxysporum. Biol. Control. 2024, 190, 105446. [Google Scholar] [CrossRef]
- Qessaoui, R.; Zanzan, M.; Ajerrar, A.; Lahmyed, H.; Boumair, A.; Tahzima, R.; Alouani, M.; Mayad, E.H.; Chebli, B.; Walters, S.A.; et al. Pseudomonas Isolates as Potential Biofungicides of Green Mold ( Penicillium digitatum ) on Orange Fruit. Int. J. Fruit. Sci. 2022, 22, 142–150. [Google Scholar] [CrossRef]
- Kaur, R.; Singh, R.; Alabouvette, C. Antagonistic Activity of Selected Isolates of Fluorescent Pseudomonas against Fusarium oxysporum f. sp. ciceri. Asian J. Plant Sci. 2007, 6, 446–454. [Google Scholar] [CrossRef]
- Samaras, A.; Karaoglanidis, G.S.; Tzelepis, G. Insights into the Multitrophic Interactions between the Biocontrol Agent Bacillus subtilis MBI 600, the Pathogen Botrytis cinerea and Their Plant Host. Microbiol. Res. 2021, 248, 126752. [Google Scholar] [CrossRef] [PubMed]
- Castric, P.A. Hydrogen Cyanide, a Secondary Metabolite of Pseudomonas aeruginosa. J. Microbiol. 1975, 21, 613–618. [Google Scholar] [CrossRef] [PubMed]
- Tsegaye, Z.; Feleke, A.; Alemu, T.; Assefa, F. Screening and Biochemical Identification of Tef (Eragrostis tef Zucc.) Trotter) Endophytic Bacterial Species with Plant-Growth-Promoting, Biotic and Abiotic Stress Tolerance Properties. J. Sci. 2019, 10, 21. [Google Scholar] [CrossRef]
- Veerapagu, M.; Sankara Narayanan, D.A.; Ponmurugan, K.; Jeya, K.R. Screening Selection Identification Production and Optimization of Bacterial Lipase from Oil Spilled Soil. Asian J. Pharm. Clin. Res. 2013, 6, 62–67. [Google Scholar]
- Yahia, M.; Mohamed, M.; Othman, M.; Mostafa, D.; Gomaa, M.; Fahmy, M.; Shaban, R.; Kamel, A.; Abdelhai, M.; Radwan, W.; et al. Isolation and identification of antibiotic producing Pseudomonas fluorescens nbrc-14160 from delta soil in Egypt. Arab. Univ. J. Agric. Sci. 2020, 28, 797–808. [Google Scholar] [CrossRef]
- Masi, C.; Gemechu, G.; Tafesse, M. Isolation, Screening, Characterization, and Identification of Alkaline Protease-Producing Bacteria from Leather Industry Effluent. Ann. Microbiol. 2021, 71, 24. [Google Scholar] [CrossRef]
- Admassie, M.; Woldehawariat, Y.; Alemu, T.; Cantore, S. In Vitro Evaluation of Extracellular Enzyme Activity and Its Biocontrol Efficacy of Bacterial Isolates from Pepper Plants for the Management of Phytophthora capsici. BioMed Res. Int. 2022, 2022, 6778352. [Google Scholar] [CrossRef]
- Mahawer, A.K.; Dubey, A.K.; Awasthi, O.P.; Singh, D.; Dahuja, A.; Sevanthi, A.M.; Kumar, A.; Goswami, A.K.; Sharma, N.; Yadav, J.; et al. Elucidation of Physio-Biochemical Changes in Citrus spp. Incited by Xanthomonas citri pv. citri. Horticulturae 2023, 9, 324. [Google Scholar] [CrossRef]
- Cattelan, A.J.; Hartel, P.G.; Fuhrmann, J.J. Screening for Plant Growth–Promoting Rhizobacteria to Promote Early Soybean Growth. Soil Sci. Soc. Am. J. 1999, 63, 1670–1680. [Google Scholar] [CrossRef]
- Elshafie, H.S.; Camele, I.; Racioppi, R.; Scrano, L.; Iacobellis, N.S.; Bufo, S.A. In Vitro Antifungal Activity of Burkholderia gladioli pv. agaricicola against Some Phytopathogenic Fungi. Int. J. Mol. Sci. 2012, 13, 16291–16302. [Google Scholar] [CrossRef] [PubMed]
- Dinesh, R.; Anandaraj, M.; Kumar, A.; Bini, Y.K.; Subila, K.P.; Aravind, R. Isolation, Characterization, and Evaluation of Multi-Trait Plant Growth Promoting Rhizobacteria for Their Growth Promoting and Disease Suppressing Effects on Ginger. Microbiol. Res. 2015, 173, 34–43. [Google Scholar] [CrossRef] [PubMed]
- Zahoor, S.; Naz, R.; Keyani, R.; Roberts, T.H.; Hassan, M.N.; Yasmin, H.; Nosheen, A.; Farman, S. Rhizosphere Bacteria Associated with Chenopodium Quinoa Promote Resistance to Alternaria alternata in Tomato. Sci. Rep. 2022, 12, 19027. [Google Scholar] [CrossRef]
- Hankin, L.; Zucker, M.; Sands, D.C. Improved Solid Medium for the Detection and Enumeration of Pectolytic Bacteria. Appl. Microbiol. 1971, 22, 205–209. [Google Scholar] [CrossRef]
- Kesharwani, A.K.; Singh, D.; Kulshreshtha, A.; Kashyap, A.S.; Avasthi, A.S.; Geat, N. Black Rot Disease Incited by Indian Race 1 of Xanthomonas campestris Pv. campestris in Brassica juncea ‘Pusa Bold’ in India. Plant Dis. 2023, 107, 212. [Google Scholar] [CrossRef] [PubMed]
- Schinke, C.; Germani, J.C. Screening Brazilian Macrophomina phaseolina Isolates for Alkaline Lipases and Other Extracellular Hydrolases. Int. Microbiol. 2012, 15, 1–7. [Google Scholar] [CrossRef]
- Dewi, R.T.K.; Mubarik, N.R.; Suhartono, M.T. Medium Optimization of β-Glucanase Production by Bacillus subtilis SAHA 32.6 Used as Biological Control of Oil Palm Pathogen. Emir. J. Food Agric. 2016, 28, 116–125. [Google Scholar] [CrossRef]
- Ram, D.; Devi, T.P.; Koti, P.S.; Jeevan, B.; Kamil, D.; Vanapalli, C.S.; Raghu, S.; Sunani, S.K.; Kashyap, A.S. Exploring the Taxonomic Classification of Curvularia genera: Enhancing Understanding of Phytopathogenic Species in Poaceae through Morphological and Molecular Approaches. J. Plant Pathol. 2024, 106, 539–551. [Google Scholar] [CrossRef]
- Jatoth, R.; Kashyap, A.S.; Babu, P.L.; Singh, D.; Gogoi, R.; Manzar, N.; Geat, N.; Muthusamy, V.; Padaria, J.C. Unravelling the Aetiology of Dickeya zeae Using Polyphasic Approaches for Bacterial Stalk Rot in Maize. Plant Pathol. 2024, 73, 1007–1022. [Google Scholar] [CrossRef]
- Wu, S.; Cao, Z.; Li, Z.; Cheung, K.; Wong, M. Effects of Biofertilizer Containing N-Fixer, P and K Solubilizers and AM Fungi on Maize Growth: A Greenhouse Trial. Geoderma 2005, 125, 155–166. [Google Scholar] [CrossRef]
- Lugtenberg, B.J.; Chin-A-Woeng, T.F.; Bloemberg, G.V. Microbe-Plant Interactions: Principles and Mechanisms. Int. J. Gen. Mol. Microbiol. 2002, 81, 373–383. [Google Scholar] [CrossRef] [PubMed]
- Kashyap, A.S.; Manzar, N. Molecular Characterization and Biocontrol Potential of rhizospheric Trichoderma and Bacillus spp. from Indo-Gangetic Plains with Botanical Applications against Bipolaris sorokiniana in Wheat. Physiol. Mol. Plant Pathol. 2025, 136, 1002567. [Google Scholar] [CrossRef]
- Gholami, A.; Shahsavani, S.; Nezarat, S. The Effect of Plant Growth Promoting Rhizobacteria (PGPR) on Germination, Seedling Growth and Yield of Maize. Int. J. Biol. Sci. 2009, 3, 9–14. [Google Scholar]
- Mehmood, N.; Saeed, M.; Zafarullah, S.; Hyder, S.; Rizvi, Z.F.; Gondal, A.S.; Jamil, N.; Iqbal, R.; Ali, B.; Ercisli, S.; et al. Multifaceted Impacts of Plant-Beneficial Pseudomonas spp. in Managing Various Plant Diseases and Crop Yield Improvement. ACS Omega 2023, 8, 22296–22315. [Google Scholar] [CrossRef] [PubMed]
- Glick, B.R. The Enhancement of Plant Growth by Free-Living Bacteria. Can. J. Microbiol. 1995, 41, 109–117. [Google Scholar] [CrossRef]
- Etesami, H.; Adl, S.M. Plant Growth-Promoting Rhizobacteria (PGPR) and Their Action Mechanisms in Availability of Nutrients to Plants. In Phyto-Microbiome in Stress Regulation; Springer: Singapore, 2020; pp. 147–203. [Google Scholar]
- Chen, Y.; Rekha, P.; Arun, A.; Shen, F.; Lai, W.-A.; Young, C. Phosphate Solubilizing Bacteria from Subtropical Soil and Their Tricalcium Phosphate Solubilizing Abilities. Appl. Soil Ecol. 2006, 34, 33–41. [Google Scholar] [CrossRef]
- Patel, D.K.; Archana, G.; Kumar, G.N. Variation in the Nature of Organic Acid Secretion and Mineral Phosphate Solubilization by Citrobacter sp. DHRSS in the Presence of Different Sugars. Curr. Microbiol. 2007, 56, 168–174. [Google Scholar] [CrossRef]
- Rodríguez, H.; Fraga, R. Phosphate Solubilizing Bacteria and Their Role in Plant Growth Promotion. Biotechnol. Adv. 1999, 17, 319–339. [Google Scholar] [CrossRef]
- Rodríguez, H.; Fraga, R.; Gonzalez, T.; Bashan, Y. Genetics of Phosphate Solubilization and Its Potential Applications for Improving Plant Growth-Promoting Bacteria. Plant Soil 2006, 287, 15–21. [Google Scholar] [CrossRef]
- Brígido, C.; Glick, B.R.; Oliveira, S. Survey of Plant Growth-Promoting Mechanisms in Native Portuguese Chickpea Mesorhizobium Isolates. Microb. Ecol. 2016, 73, 900–915. [Google Scholar] [CrossRef]
- Sadfi-Zouaoui, N.; Essghaier, B.; Hannachi, I.; Hajlaoui, M.R.; Boudabous, A. First Report on the Use of Moderately Halophilic Bacteria against Stem Canker of Greenhouse Tomatoes Caused by Botrytis cinerea. Ann. Microbiol. 2007, 57, 337–339. [Google Scholar] [CrossRef]
- Duca, D.; Lorv, J.; Patten, C.L.; Rose, D.; Glick, B.R. Indole-3-Acetic Acid in Plant-Microbe Interactions. Int. J. Gen. Mol. Microbiol. 2014, 106, 85–125. [Google Scholar] [CrossRef] [PubMed]
- Chen, Y.; Yang, W.; Chao, Y.; Wang, S.; Tang, Y.-T.; Qiu, R.-L. Metal-Tolerant Enterobacter sp. Strain EG16 Enhanced Phytoremediation Using Hibiscus cannabinus via Siderophore-Mediated Plant Growth Promotion under Metal Contamination. Plant Soil 2016, 413, 203–216. [Google Scholar] [CrossRef]
- Kashyap, A.S.; Manzar, N.; Vishwakarma, S.K.; Mahajan, C.; Dey, U. Tiny but Mighty: Metal Nanoparticles as Effective Antimicrobial Agents for Plant Pathogen Control. World J. Microbiol. Biotechnol. 2024, 40, 104. [Google Scholar] [CrossRef]
- Ramette, A.; Frapolli, M.; Défago, G.; Moënne-Loccoz, Y. Phylogeny of HCN Synthase-Encoding hcnBC Genes in Biocontrol Fluorescent Pseudomonads and Its Relationship with Host Plant Species and HCN Synthesis Ability. Mol. Plant-Microbe Interact. 2003, 16, 525–535. [Google Scholar] [CrossRef] [PubMed]
- Kumari, S.; Khanna, V. Effect of Antagonistic Rhizobacteria coinoculated with Mesorhizobium ciceris on Control of Fusarium Wilt in Chickpea (Cicer arietinum L.). Afr. J. Microbiol. Res. 2014, 8, 1255–1265. [Google Scholar]
- El-Tarabily, K.A. Rhizosphere-Competent Isolates of Streptomycete and Non-Streptomycete Actinomycetes Capable of Producing Cell-Wall-Degrading Enzymes to Control Pythium aphanidermatum Damping-off Disease of Cucumber. Can. J. Bot. 2006, 84, 211–222. [Google Scholar] [CrossRef]
- Sneh, B.; Dupler, M.; Elad, Y. Chlamydospore Germination of Fusarium oxysporum f. sp. cucumerinum as Affected by Fluorescent and Lytic Bacteria from a Fusarium-Suppressive Soil. Phytopathology 1984, 74, 1115–1124. [Google Scholar] [CrossRef]
- Frankowski, J.; Lorito, M.; Scala, F.; Schmid, R.; Berg, G.; Bahl, H. Purification and Properties of Two Chitinolytic Enzymes of Serratia plymuthica HRO-C48. Arch. Microbiol. 2001, 176, 421–426. [Google Scholar] [CrossRef]
- Elsharkawy, M.M.; Sakran, R.M.; Ahmad, A.A.; Behiry, S.I.; Abdelkhalek, A.; Hassan, M.M.; Khedr, A.A. Induction of Systemic Resistance against Sheath Blight in Rice by Different Pseudomonas Isolates. Life 2022, 12, 349. [Google Scholar] [CrossRef] [PubMed]
- Dobrzyński, J.; Jakubowska, Z.; Kulkova, I.; Kowalczyk, P.; Kramkowski, K. Biocontrol of Fungal Phytopathogens by Bacillus pumilus. Front. Microbiol. 2023, 14, 1194606. [Google Scholar] [CrossRef] [PubMed]
- Heidarzadeh, N.; Baghaee-Ravari, S. Application of Bacillus pumilus as a Potential Biocontrol Agent of Fusarium Wilt of Tomato. Arch. Phytopathol. Plant Prot. 2015, 48, 841–849. [Google Scholar] [CrossRef]
- Kulkova, I.; Dobrzyński, J.; Kowalczyk, P.; Bełżecki, G.; Kramkowski, K. Plant Growth Promotion Using Bacillus cereus. Int. J. Mol. Sci. 2023, 24, 9759. [Google Scholar] [CrossRef]
- Yan, P.; Ahmad, S.; Xu, Z.; Jia, H.; Zhang, R.; Song, J.; Manzar, N.; Kashyap, A.S.; Zhang, W. Isolation and Characterization of Bacillus sp. HSY32 and Its Toxin Gene for Potential Biological Control of Plant Parasitic Nematode. Chem. Biol. Technol. Agric. 2024, 11, 191. [Google Scholar] [CrossRef]
- Dobrzyński, J.; Jakubowska, Z.; Dybek, B. Potential of Bacillus pumilus to Directly Promote Plant Growth. Front. Microbiol. 2022, 13, 1069053. [Google Scholar] [CrossRef]
- Defez, R.; Andreozzi, A.; Bianco, C. The Overproduction of Indole-3-Acetic Acid (IAA) in Endophytes Upregulates Nitrogen Fixation in Both Bacterial Cultures and Inoculated Rice Plants. Microb. Ecol. 2017, 74, 441–452. [Google Scholar] [CrossRef]
- Vyas, P.; Gulati, A. Organic Acid Production in Vitro and Plant Growth Promotion in Maize under Controlled Environment by Phosphate-Solubilizing Fluorescent Pseudomonas. BMC Microbiol. 2009, 9, 174. [Google Scholar] [CrossRef]

| Nitrogen Fixation | Ammonia Production * | Phosphate Solubilization | IAA Production * | Siderophore Production * | |
|---|---|---|---|---|---|
| RP6 | - | ++ | + | ++ | - |
| RS46 | - | ++ | + | ++ | + |
| RS60 | - | ++ | + | ++ | - |
| RS65 | - | ++ | + | - | - |
| Production of Cyanide HCN * | Lipolytic Activity | Proteolytic Activity | Chitinolytic Activity | Cellulase Production | Pectinase Production | Glucanase Production | |
|---|---|---|---|---|---|---|---|
| RS60 | ++ | - | ++ | ++ | ++ | +++ | - |
| RP6 | ++ | - | ++ | + | ++ | +++ | +++ |
| RS65 | ++ | - | ++ | + | ++ | +++ | ++ |
| RS46 | - | ++ | ++ | + | ++ | - | + |
Disclaimer/Publisher’s Note: The statements, opinions and data contained in all publications are solely those of the individual author(s) and contributor(s) and not of MDPI and/or the editor(s). MDPI and/or the editor(s) disclaim responsibility for any injury to people or property resulting from any ideas, methods, instructions or products referred to in the content. |
© 2025 by the authors. Licensee MDPI, Basel, Switzerland. This article is an open access article distributed under the terms and conditions of the Creative Commons Attribution (CC BY) license (https://creativecommons.org/licenses/by/4.0/).
Share and Cite
El hjouji, H.; Qessaoui, R.; Chafiki, S.; Mayad, E.H.; Houmairi, H.; Dari, K.; Bencharki, B.; Aassila, H. Enhancement of Tomato Growth Through Rhizobacteria and Biocontrol of Associated Diseases. Life 2025, 15, 997. https://doi.org/10.3390/life15070997
El hjouji H, Qessaoui R, Chafiki S, Mayad EH, Houmairi H, Dari K, Bencharki B, Aassila H. Enhancement of Tomato Growth Through Rhizobacteria and Biocontrol of Associated Diseases. Life. 2025; 15(7):997. https://doi.org/10.3390/life15070997
Chicago/Turabian StyleEl hjouji, Hasna, Redouan Qessaoui, Salahddine Chafiki, El Hassan Mayad, Hafsa Houmairi, Khadija Dari, Bouchaib Bencharki, and Hinde Aassila. 2025. "Enhancement of Tomato Growth Through Rhizobacteria and Biocontrol of Associated Diseases" Life 15, no. 7: 997. https://doi.org/10.3390/life15070997
APA StyleEl hjouji, H., Qessaoui, R., Chafiki, S., Mayad, E. H., Houmairi, H., Dari, K., Bencharki, B., & Aassila, H. (2025). Enhancement of Tomato Growth Through Rhizobacteria and Biocontrol of Associated Diseases. Life, 15(7), 997. https://doi.org/10.3390/life15070997

